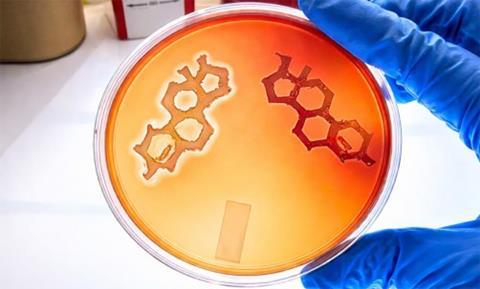
image (20)

Men are more susceptible than women to skin infections caused by Staphylococcus aureus bacteria, but the biological basis for this disparity has remained unclear. A new study led by UT Southwestern Medical Center researchers is the first to reveal testosterone, present at higher levels in males, as a key driver of infection.
The sex steroid activates a bacterial communication pathway known as quorum sensing, increasing skin cell death and promoting the destruction of red blood cells and white blood cells called neutrophils.
Published in Nature Microbiology, the study also reported that a mirror-image form of testosterone, known as an enantiomer (ent-T), blocks quorum sensing and prevents S. aureus from damaging tissue in mice models. Senior author Tamia Harris-Tryon, M.D., Ph.D., Associate Professor of Dermatology and Immunology at UT Southwestern, and first author Maria S. John, Ph.D., a UTSW postdoctoral researcher, have a patent pending for an ent-T-based therapeutic along with collaborators at the University of Colorado.
“This research has important implications for treating Staph skin infections and conditions complicated by Staphylococcus, such as atopic dermatitis, pemphigus, abscesses, and wound infections, including the deadliest skin infections caused by methicillin-resistant Staphylococcus aureus [MRSA],” Dr. Harris-Tryon said. “It also explains why men are more susceptible to Staph infections.”
Leading cause of skin infections
S. aureus is the leading cause of skin infections. When it enters the bloodstream, it can cause septicemia, a life-threatening infection that may lead to organ failure.
During infection, the bacteria use quorum sensing to detect neighboring cells of the same species. As bacterial density rises, they produce short signaling molecules called auto-inducing peptides (AIP), which activate virulence programs and trigger toxin release, resulting in host-cell damage.
The research team found that male skin cells consistently secrete higher levels of testosterone hormone than female skin cells. They also found the same is true for male mice, which were significantly more susceptible to S. aureus colonization and skin damage than female mice when exposed to a strain of MRSA. However, mice engineered to secrete less testosterone displayed greater resistance to the bacteria, while applying testosterone to the skin of female mice increased MRSA’s severity.
Quorum sensing activation
In laboratory experiments, testosterone activated quorum sensing even in the absence of AIPs. Other sex steroids, including progesterone and estrogen, had no measurable effect on quorum sensing.
While using ent-T as an experimental control, the researchers unexpectedly identified its therapeutic potential. In lab tests, ent-T inhibited quorum sensing and reduced the bacteria’s virulence. The molecule also inhibited quorum sensing on male and female mice when applied to their skin.
READ MORE: The birds, the bees, and the bugs: how gut microbes impact sex hormones and reproductive health
READ MORE: Women are three times more likely than men to get severe long COVID: Here’s why
Dr. Harris-Tryon won an Innovation Award from the UTSW Office for Technology Development in 2024 to fund development of an ent-T-based transdermal therapeutic for Staph.
“Our exciting finding suggests we can inhibit S. aureus virulence rather than killing the bacteria directly, an approach that prevents infection, preserves beneficial skin microbes, and reduces the selective pressure that drives antibiotic resistance while offering a potential new strategy to treat infections, including MRSA,” Dr. John said.
Study background
This work builds on Dr. Harris-Tryon’s studies in 2023 and 2025 with Jeffrey McDonald, Ph.D., Professor in the Center for Human Nutrition and of Molecular Genetics at UTSW, that demonstrated sex-specific differences in skin hormone production. The team also has previously uncovered how the immune system stimulates testosterone production in skin cells. Dr. Harris-Tryon said the current research builds on UT Southwestern’s longstanding leadership in steroid and skin hormone biology, a field in which the institution has been a global leader for decades.
A complete list of authors from UTSW can be found in the study.
Dr. Harris-Tryon holds the Thomas L. Shields, M.D. Professorship in Dermatology.
This research was funded by grants from the National Institutes of Health (NIAMS-K08AR076459, NIAID-AI162964, NIAID-AI153185, and NIAID-AI187273), the VA Merit Award (BX002711), and the Burroughs Wellcome Fund (1022777).
No comments yet